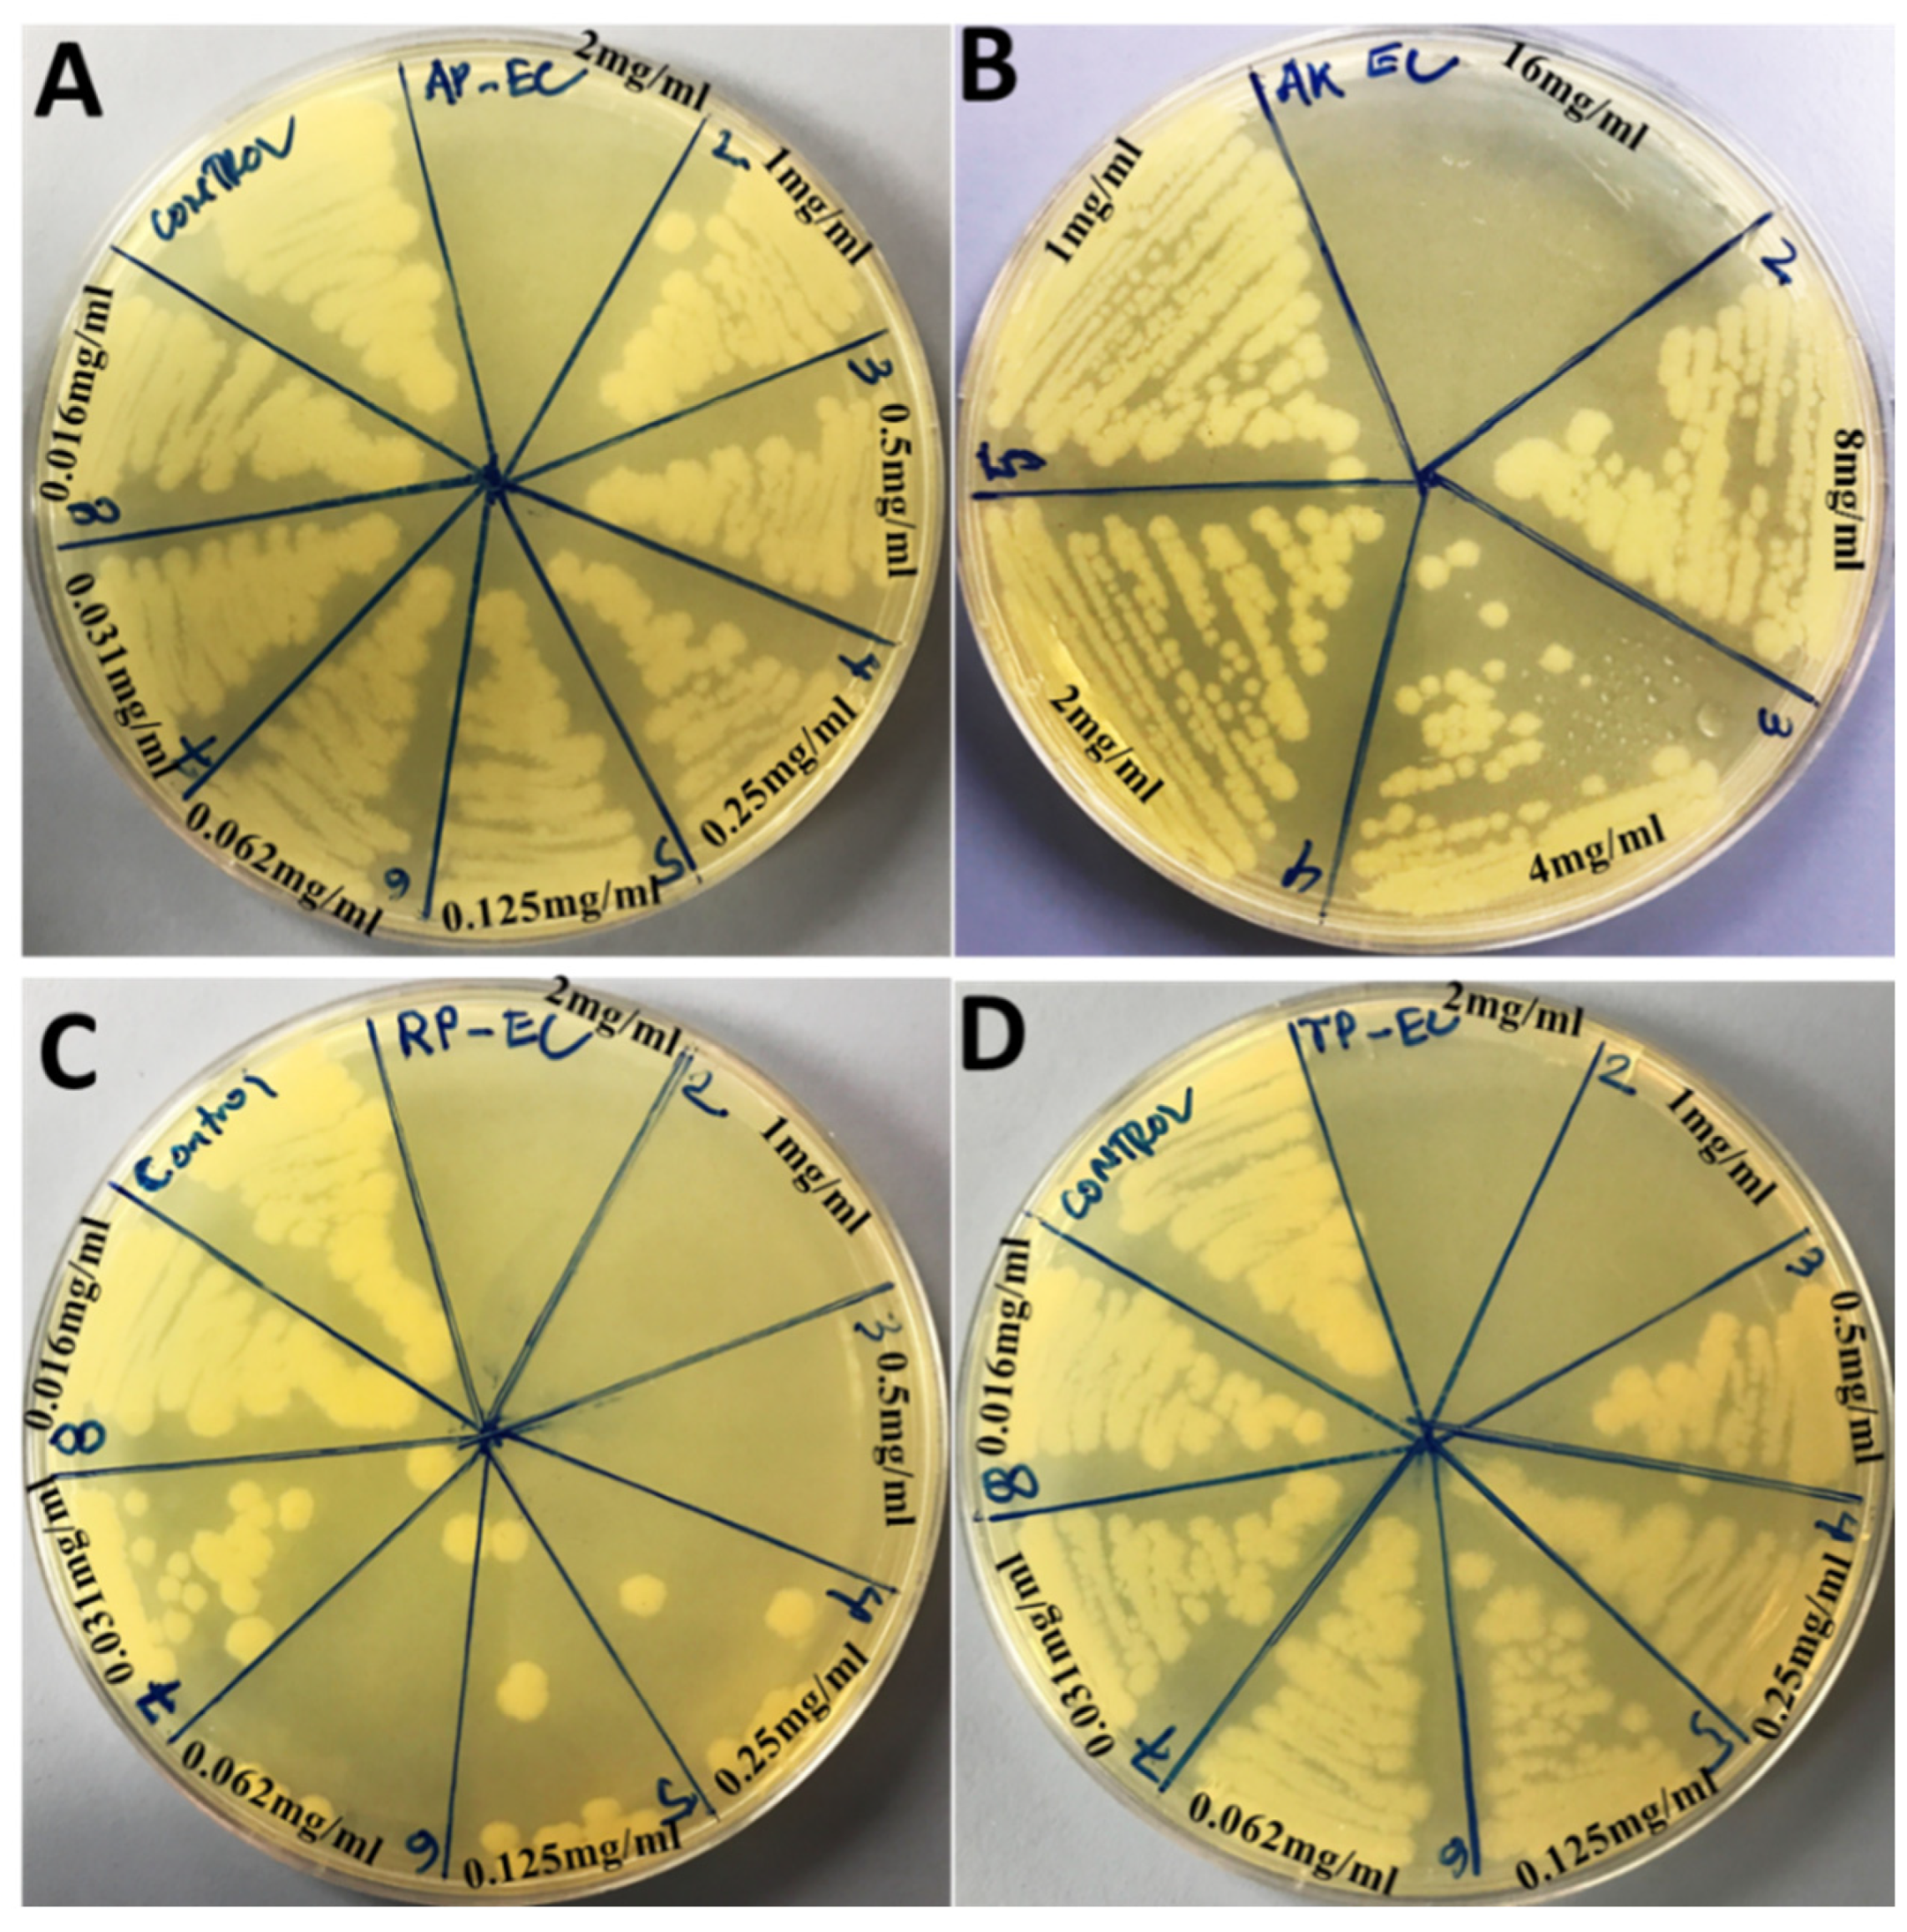
Ijms 23 11403 g003
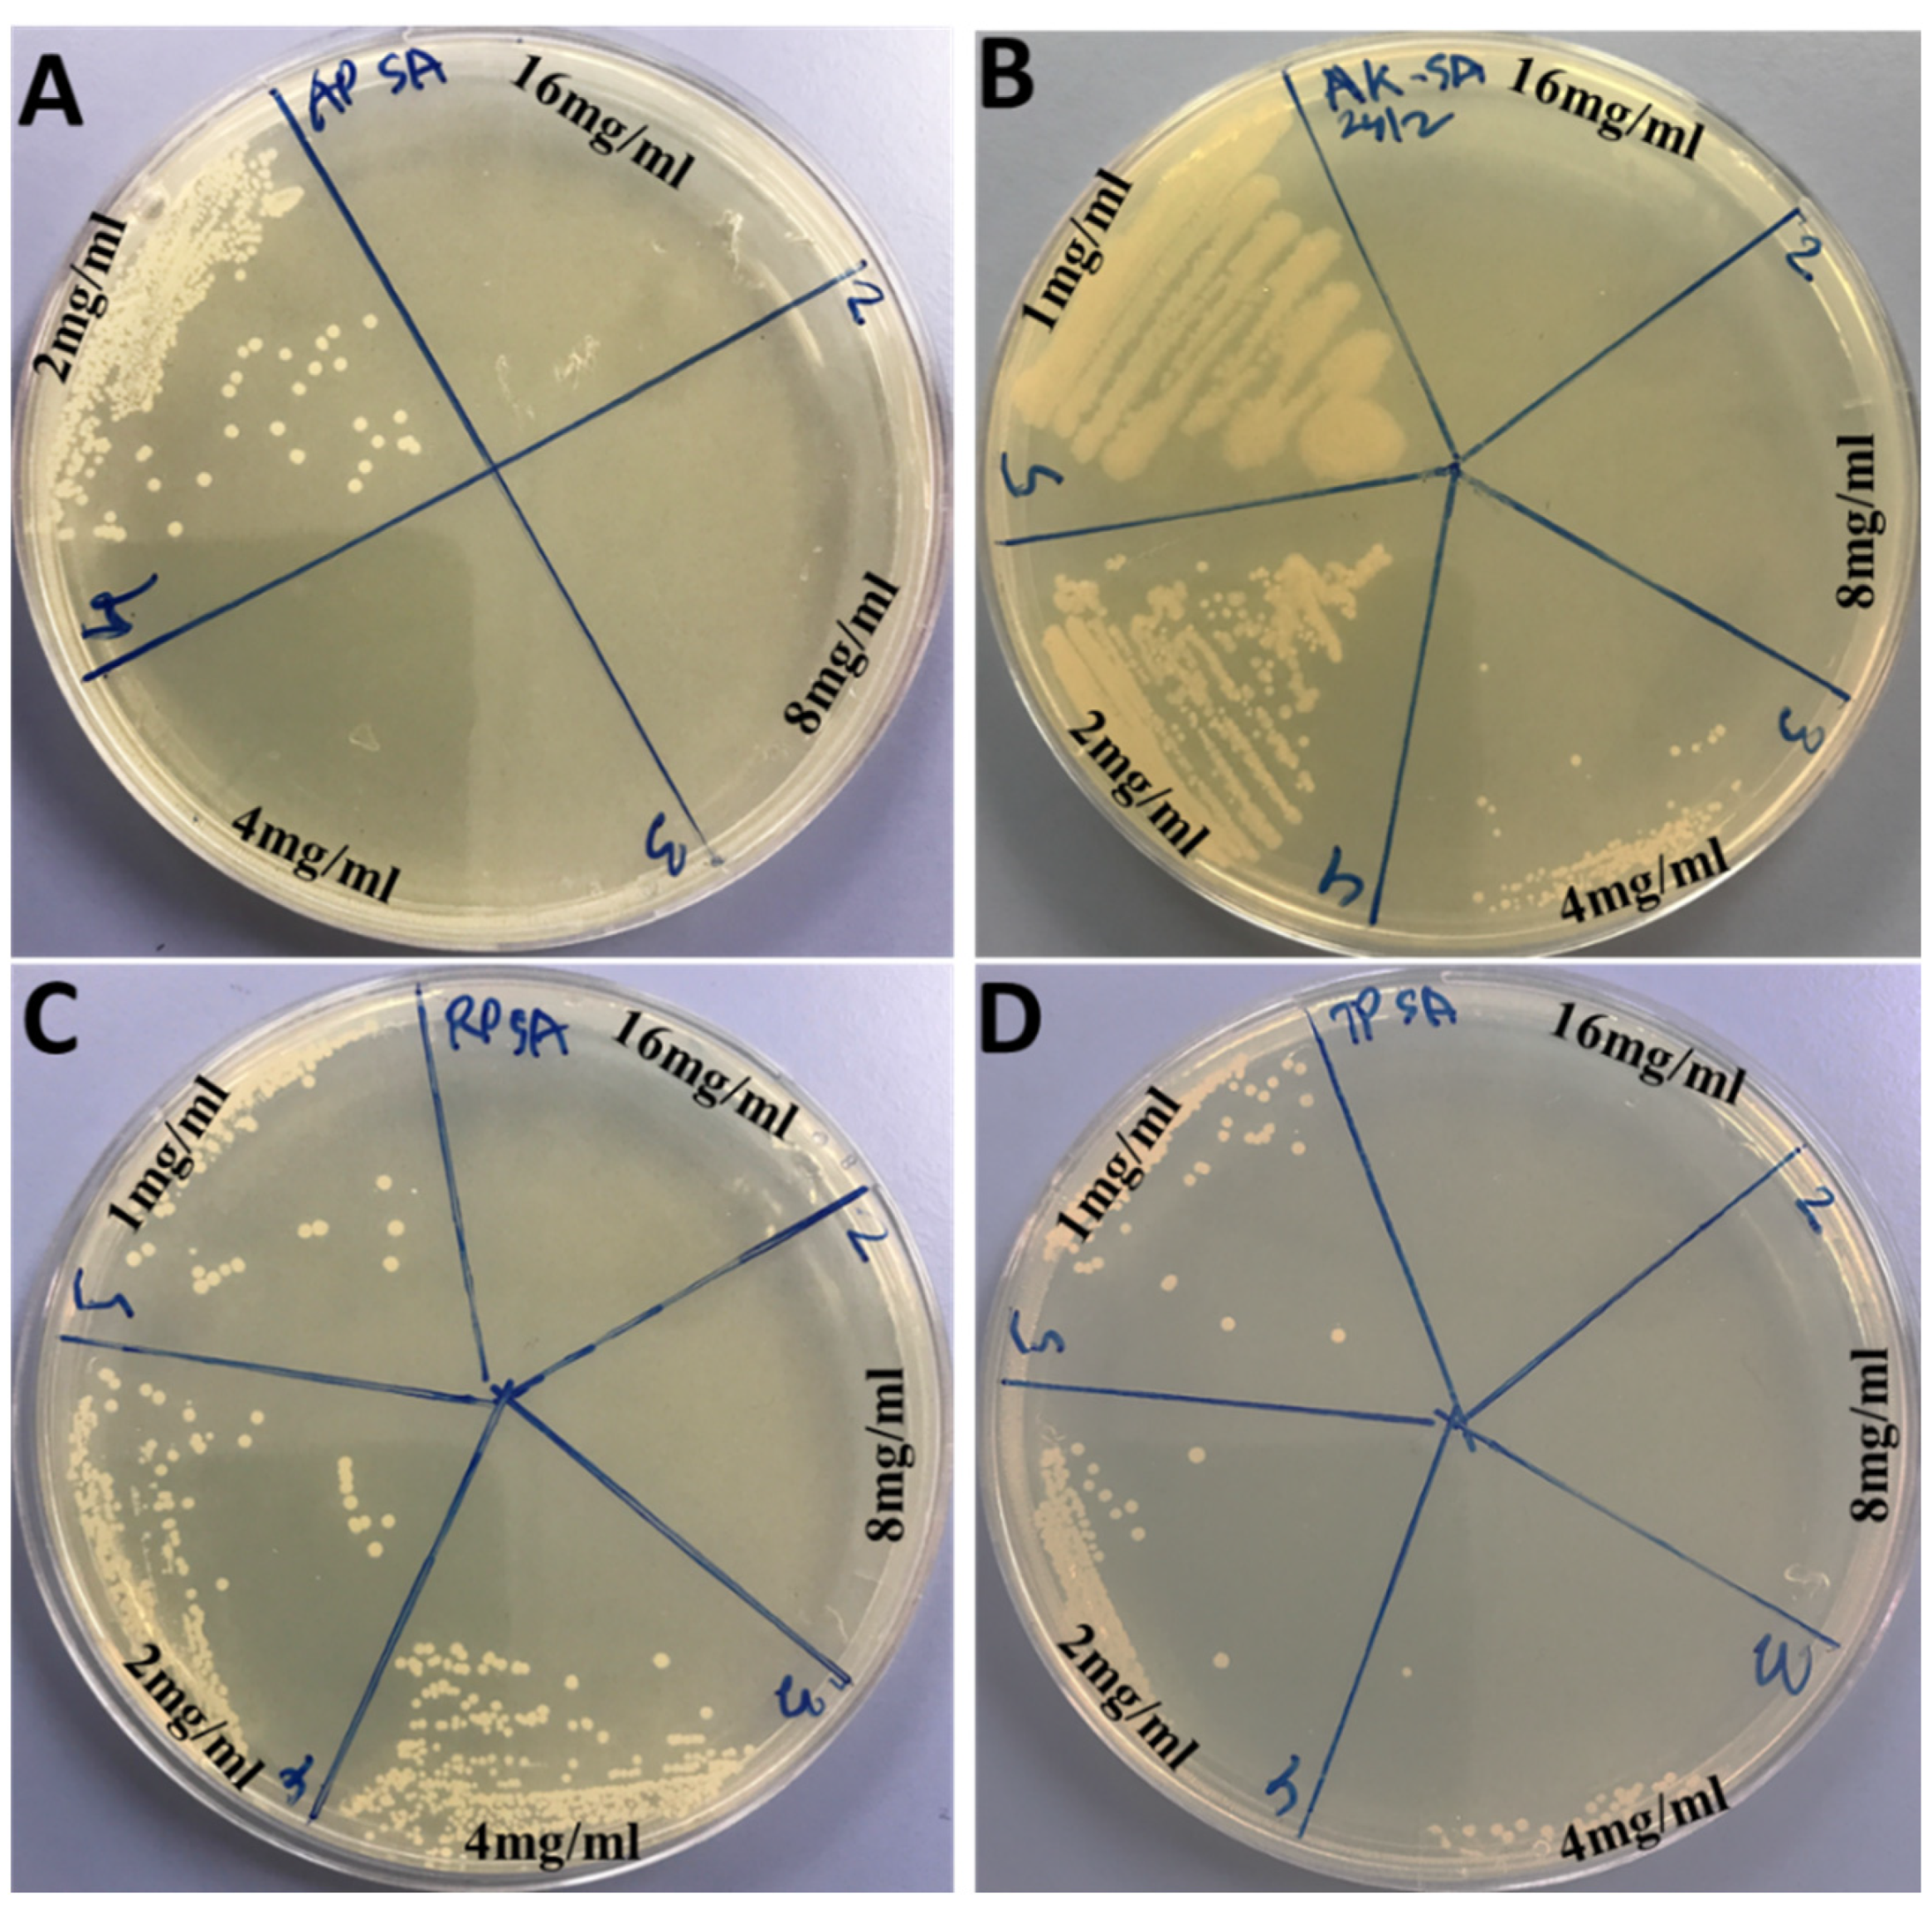
Ijms 23 11403 g004

Synthesis of M-Ag3PO4, (M = Se, Ag, Ta) Nanoparticles and Their Antibacterial and Cytotoxicity Study
Abstract
1. Introduction
2. Results and Discussion
2.1. Characterization of Ag3PO4, Se-Ag3PO4, Ag-Ag3PO4, and Ta-Ag3PO4 Nanoparticles
2.2. Antibacterial Activity Ag3PO4, Se-Ag3PO4, Ag-Ag3PO4, and Ta-Ag3PO4 Nanoparticles
2.3. Effects of Compounds on Bacteria Growth after Application of Sonication
2.4. Effect of Ag3PO4, Se-Ag3PO4, Ag-Ag3PO4, Ta-Ag3PO4 on Cancer Cells Viability
2.5. Apoptotic Effect of Ag3PO4, Se-Ag3PO4, Ag-Ag3PO4, Ta-Ag3PO4
3. Experimental
3.1. Materials and Methods
3.1.1. Preparation of Ag3PO4, Se-Ag3PO4, Ag-Ag3PO4, and Ta-Ag3PO4 Nanoparticles
3.1.2. Characterization of Ag3PO4, Se-Ag3PO4, Ag-Ag3PO4, and Ta-Ag3PO4 Nanoparticles
3.1.3. Antibacterial Activity of Ag3PO4, Se-Ag3PO4, Ag-Ag3PO4, and Ta-Ag3PO4 Nanoparticles
3.1.4. Minimal Inhibitory and Minimal Bactericidal Concentration (MIC & MBC)
3.1.5. Synergistic Effects of Nanocomposites and Sonication on Bacteria Growth
3.2. Cytotoxicity of Ag3PO4, Se-Ag3PO4, Ag-Ag3PO4, and Ta-Ag3PO4
3.2.1. In Vitro Culture and Testing by MTT Method
3.2.2. Apoptotic Morphology by DAPI Staining
4. Conclusions
Supplementary Materials
Author Contributions
Funding
Institutional Review Board Statement
Informed Consent Statement
Data Availability Statement
Acknowledgments
Conflicts of Interest
References
- Lu, Y.; Wan, X.; Li, L.; Sun, P.F.; Liu, G. Synthesis of a reusable composite of graphene and silver nanoparticles for catalytic reduction of 4-nitrophenol and performance as anti-colorectal carcinoma. J. Mater. Res. Technol. 2021, 12, 1832–1843. [Google Scholar] [CrossRef]
- Qureshi, F.; Nawaz, M.; Rehman, S.; Almofty, S.A.; Shahzad, S.; Nissapatorn, V.; Taha, M. Synthesis and characterization of cadmium-bismuth microspheres for the catalytic and photocatalytic degradation of organic pollutants, with antibacterial, antioxidant and cytotoxicity assay. J. Photochem. Photobiol. B 2020, 202, 111723. [Google Scholar] [CrossRef] [PubMed]
- Nawaz, M.; Akhtar, S.; Qureshi, F.; Almofty, S.A.; Nissapatron, V. Preparation of indium-cadmium sulfide nanoparticles with diverse morphologies: Photocatalytic and cytotoxicity study. J. Mol. Struct. 2022, 1253, 132288. [Google Scholar] [CrossRef]
- Abebe, B.; Murthy, H.C.A.; Dessie, Y. Synthesis and characterization of Ti–Fe oxide nanomaterials: Adsorption–degradation of methyl orange dye. Arab. J. Sci. Eng. 2020, 45, 4609–4620. [Google Scholar] [CrossRef]
- Liu, Y.Y.; Guo, X.; Chen, Z.; Zhang, W.; Wang, Y.; Zheng, Y.; Tang, X.; Zhang, M.; Peng, Z.; Li, R.; et al. Microwave-synthesis of g-C3N4 nanoribbons assembled seaweed-like architecture with enhanced photocatalytic property. Appl. Catal. B Environ. 2020, 266, 118624. [Google Scholar] [CrossRef]
- Liao, S.H.; Liu, C.H.; Bastakoti, B.P.; Suzuki, N.; Chang, Y.; Yamauchi, Y.; Wu, K.C. Pulmonary protective effects of ultrasonic green synthesis of gold nanoparticles mediated by pectin on Methotrexate-induced acute lung injury in lung BEAS-2B, WI-38, CCD-19Lu, IMR-90, MRC-5, and HEL 299 cell lines. Int. J. Nanomed. 2015, 10, 3315–3327. [Google Scholar]
- Veisi, H.; Najafi, S.; Hemmati, S. Pd(II)/Pd(0) anchored to magnetic nanoparticles (Fe3O4) modified with biguanidine-chitosan polymer as a novel nanocatalyst for Suzuki-Miyaura coupling reactions. Int. J. Biol. Macromol. 2018, 113, 186–194. [Google Scholar] [CrossRef]
- Arunachalam, K.D.; Annamalai, S.K.; Hari, S. One-step green synthesis and characterization of leaf extract-mediated biocompatible silver and gold nanoparticles from Memecylon umbellatum. Int. J. Nanomed. 2003, 8, 1307–1315. [Google Scholar] [CrossRef]
- You, C.; Han, C.; Wang, X.; Zheng, Y.; Li, Q.; Hu, X.; Sun, H. The progress of silver nanoparticles in the antibacterial mechanism, clinical application and cytotoxicity. Mol. Biol. Rep. 2012, 39, 9193–9201. [Google Scholar] [CrossRef]
- Mao, B.-H.; Tsai, J.-C.; Chen, C.-W.; Yan, S.-J.; Wang, Y.-J. Mechanisms of silver nanoparticle-induced toxicity and important role of autophagy. Nanotoxicology 2016, 10, 1021–1040. [Google Scholar] [CrossRef]
- Mahboob, T.; Nawaz, M.; Pereira, M.L.; Tan, T.C.; Samudi, C.; Sekaran, S.D.; Wiart, C.; Nissapatorn, V. PLGA nanoparticles loaded with Gallic acid- a constituent of Leea indica against Acanthamoeba triangularis. Sci. Rep. 2020, 10, 8954. [Google Scholar] [CrossRef] [PubMed]
- Jannat, K.; Paul, A.K.; Bondhon, T.A.; Hasan, A.; Nawaz, M.; Jahan, R.; Mahboob, T.; Nissapatorn, V.; Wilairatana, P.; Pereira, M.L.; et al. Nanotechnology applications of flavonoids for viral diseases. Pharmaceutics 2021, 13, 1895. [Google Scholar] [CrossRef] [PubMed]
- Al-Suhaimi, E.A.; Firdos, A.; Khan, F.A.; Aljafary, M.A.; Baykal, A.; Homeida, A.M. Emerging trends in the delivery of nanoformulated oxytocin across Blood-Brain barrier. Int. J. Pharm. 2021, 609, 121–141. [Google Scholar] [CrossRef] [PubMed]
- Lim, C.L.; Raju, C.S.; Mahboob, T.; Kayesth, S.; Gupta, K.; Jain, G.K.; Dhobi, M.; Nawaz, M.; Wilairatana, P.; Pereira, M.L.; et al. Precision and Advanced Nano-Phytopharmaceuticals for Therapeutic Applications. Nanomaterials 2022, 12, 238. [Google Scholar] [CrossRef]
- De Jong, W.H.; Borm, P.J. Drug delivery and nanoparticles: Applications and hazards. Int. J. Nanomed. 2008, 3, 133–149. [Google Scholar] [CrossRef]
- Borm, P.J.; Robbins, D.; Haubold, S.; Kuhlbusch, T.; Fissan, H.; Donaldson, K.; Schins, R.; Stone, V.; Kreyling, W.; Lademann, J.; et al. The potential risks of nanomaterials: A review carried out for ECETOC. Part. Fibre Toxicol. 2006, 3, 11. [Google Scholar] [CrossRef]
- Patra, J.K.; Das, G.; Fraceto, L.F.; Campos, E.V.R.; Rodriguez-Torres, M.D.P.; Acosta-Torres, L.S.; Diaz Torres, L.A.; Grillo, R.; Swamy, M.K.; Sharma, S.; et al. Nano based drug delivery systems: Recent developments and future prospects. J. Nanobiotechnol. 2018, 16, 71. [Google Scholar] [CrossRef]
- Stapleton, P.A.; Nurkiewicz, T.R. Vascular distribution of nanomaterials. Wiley Interdiscip. Rev. Nanomed. Nanobiotechnol. 2014, 6, 338–348. [Google Scholar] [CrossRef]
- Habibi-Yangjeh, A.; Asadzadeh-Khaneghah, S.; Feizpoor, S.; Rouhi, A. Review on heterogeneous photocatalytic disinfection of waterborne, airborne, and foodborne viruses: Can we win against pathogenic viruses? J. Colloid Interface Sci. 2020, 580, 503–514. [Google Scholar] [CrossRef]
- Hong, X.; Li, M.; Shan, S.; Hui, K.S.; Mo, M.; Yuan, X. Chloride ion-driven transformation from Ag3PO4 to AgCl on the hydroxyapatite support and its dual antibacterial effect against Escherichia coli under visible light irradiation. Environ. Sci. Pollut. Res. Int. 2016, 23, 13458–13466. [Google Scholar] [CrossRef]
- Pant, B.; Park, M.; Park, S.-J. One-step synthesis of silver nanoparticles embedded polyurethane nano-fiber/net structured membrane as an effective antibacterial medium. Polymers 2019, 11, 1185. [Google Scholar] [CrossRef] [PubMed]
- Shen, W.; Li, P.; Feng, H.; Ge, Y.; Liu, Z.; Feng, L. The bactericidal mechanism of action against Staphylococcus aureus for AgO nanoparticles. Mater. Sci. Eng. C 2017, 75, 610–619. [Google Scholar] [CrossRef] [PubMed]
- Thiyagarajan, S.; Singh, S.; Bahadur, D. Reusable sunlight activated photocatalyst Ag3PO4 and its significant antibacterial activity. Mater. Chem. Phys. 2016, 173, 385–394. [Google Scholar] [CrossRef]
- Xue, J.; Zan, G.; Wu, Q.; Deng, B.; Zhng, Y.; Huang, H.; Zhang, X. Integrated nanotechnology for synergism and degradation of fungicide SOPP using micro/nano-Ag3PO4. Inorg. Chem. Front. 2016, 3, 354–364. [Google Scholar] [CrossRef]
- Panthi, G.; Ranjit, R.; Kim, H.Y.; Mulmi, D.D. Size dependent optical and antibacterial properties of Ag3PO4 synthesized by facile precipitation and colloidal approach in aqueous solution. Optik 2018, 156, 60–68. [Google Scholar] [CrossRef]
- Wu, A.; Tian, C.; Chang, W.; Hong, Y.; Zhang, Q.; Qu, Y.; Fu, H. Morphology-controlled synthesis of Ag3PO4 nano/microcrystals and their antibacterial properties. Mater. Res. Bull. 2013, 48, 3043–3048. [Google Scholar] [CrossRef]
- Trench, A.B.; Machado, T.R.; Gouveia, A.F.; Foggi, C.C.; Teodoro, V.; Sánchez-Montes, I.; Teixeira, M.M.; da Trindade, L.G.; Jacomaci, N.; Perrin, A.; et al. Rational Design of W-Doped Ag3PO4 as an Efficient Antibacterial Agent and Photocatalyst for Organic Pollutant Degradation. ACS Omega 2020, 5, 23808–23821. [Google Scholar] [CrossRef]
- Shao, J.; Ma, J.; Lin, L.; Wang, B.; Jansen, J.A.; Walboomers, X.F.; Zuo, Y.; Yang, F. Three-dimensional Printing of Drug-loaded Scaffolds for Antibacterial and Analgesic Applications. Tissue Eng. Part C 2019, 25, 222–231. [Google Scholar] [CrossRef]
- Zhang, Y.; Zhang, X.; Hu, R.; Yang, Y.; Li, P.; Wu, Q. Bifunctional Nano-Ag3PO4 with Capabilities of Enhancing Ceftazidime for Sterilization and Removing Residues. RSC Adv. 2019, 9, 17913–17920. [Google Scholar] [CrossRef]
- Zhuang, J.; Liu, J.; Wu, Z.; Li, Z.; Zhu, K.; Yan, K.; Xu, Y.; Huang, Y.; Lin, Z. Formation of Ag3PO4/AgBr composites with Z-scheme configuration by an in situ strategy and their superior photocatalytic activity with excellent anti-photocorrosion performance. J. Mater. Sci. Mater. Electron. 2019, 30, 11368–11377. [Google Scholar] [CrossRef]
- Gao, R.; Song, J.; Hu, Y.; Zhang, X.; Gong, S.; Li, W. Facile Synthesis of Ag/Ag3PO4 Composites with Highly Efficient and Stable Photocatalytic Performance under Visible Light. J. Chin. Chem. Soc. 2017, 64, 1172–1180. [Google Scholar] [CrossRef]
- Xiaohong, W.; Jian, J.; Zhengqiu, Y.; Jianxian, Z.; Lei, Z.; Taofen, W.; Hu, Z. In situ loading of polyurethane/negative ion powder composite film with visible-light-responsive Ag3PO4@AgBr particles for photocatalytic and antibacterial applications. Eur. Polym. J. 2020, 125, 109515. [Google Scholar]
- Hossein, B.; Mohammad, A.Z.; Vahid, V. Antibacterial and antifouling properties of Ag3PO4/GO nanocomposite blended polyethersulfone membrane applied in dye separation. J. Water Process Eng. 2020, 38, 101638. [Google Scholar]
- Kaili, M.; Yao, Z.; Xiaoying, Z.; Jian, R.; Fengxian, Q.; Huayou, C.; Jinchao, X.; Dongya, Y.; Tao, Z. Effective loading of well-doped ZnO/Ag3PO4 nanohybrids on magnetic core via one step for promoting its photocatalytic antibacterial activity. Colloids Surf. A 2020, 603, 125187. [Google Scholar]
- Qinqing, W.; Shuting, J.; Suyun, L.; Xueqing, Z.; Junhui, Y.; Pei, L.; Wenyan, S.; Minghong, W.; Longxiang, S. Electrospinning visible light response Bi2MoO6/Ag3PO4 composite photocatalytic nanofibers with enhanced photocatalytic and antibacterial activity. App. Surf. Sci. 2021, 569, 150955. [Google Scholar]
- Lyu, Y.; Wei, F.; Zhang, T.; Luo, L.; Pan, Y.; Yang, X.; Yu, H.; Zhou, S. Different antibacterial effect of Ag3PO4/TiO2 heterojunctions and the TiO2 polymorphs. J. Alloys Comp. 2021, 876, 160016. [Google Scholar] [CrossRef]
- Wang, X.; Utsumi, M.; Yang, Y.; Li, D.; Zhao, Y.; Zhang, Z.; Feng, C.; Sugiura, N.; Cheng, J.J. Degradation of microcystin-LR by highly efficient AgBr/Ag3PO4/TiO2 heterojunction photocatalyst under simulated solar light irradiation. Appl. Surf. Sci. 2015, 325, 1–12. [Google Scholar] [CrossRef]
- Liu, Y.; Fang, L.; Lu, H.; Liu, L.; Wang, H.; Hu, C. Highly efficient and stable Ag/Ag3PO4 plasmonic photocatalyst in visible light. Catal. Commun. 2012, 17, 200–204. [Google Scholar] [CrossRef]
- Filipović, N.; Ušjak, D.; Milenković, M.T.; Zheng, K.; Liverani, L.; Boccaccini, A.R.; Stevanović, M.M. Comparative study of the antimicrobial activity of selenium nanoparticles with different surface chemistry and structure. Front. Bioeng. Biotechnol. 2021, 8, 624621. [Google Scholar] [CrossRef]
- Geoffrion, L.D.; Hesabizadeh, T.; Medina-Cruz, D.; Kusper, M.; Taylor, P.; Vernet-Crua, A.; Chen, J.; Ajo, A.; Webster, T.J.; Guisbiers, G. Naked selenium nanoparticles for antibacterial and anticancer treatments. ACS Omega 2020, 5, 2660–2669. [Google Scholar]
- Harrison, P.L.; Harrison, T.; Stockley, I.; Smith, T.J. Does tantalum exhibit any intrinsic antimicrobial or antibiofilm properties? Bone Joint J. 2017, 99, 1153–1156. [Google Scholar] [CrossRef] [PubMed]
- Lin, L.; Wan, H.; Mia, R.; Jiang, H.; Liu, H.; Mahmud, S. Bioreduction and Stabilization of Antibacterial Nanosilver Using Radix Lithospermi Phytonutrients for Azo-contaminated Wastewater Treatment: Synthesis, Optimization and Characterization. J. Clust. Sci. 2022. [Google Scholar] [CrossRef]
- Wang, H.; Zhang, G.; Mia, R.; Wang, W.; Xie, L.; Lü, S.; Mahmud, S.; Liu, H. Bioreduction (Ag+ to Ag0) and stabilization of silver nanocatalyst using hyaluronate biopolymer for azo-contaminated wastewater treatment. J. Alloys Compd. 2022, 894, 162502. [Google Scholar] [CrossRef]
- Mia, R.; Sk, S.; Oli, Z.B.S.; Ahmed, T.; Kabir, S.; Waqar, A. Functionalizing cotton fabrics through herbally synthesized nanosilver. Cleaner Eng. Technol. 2021, 4, 100227. [Google Scholar] [CrossRef]
- Zhang, G.; Wan, H.; Mia, R.; Huang, Q.; Liu, H.; Mahmud, S. Fabrication and stabilization of nanosilver using Houttugniae for antibacterial and catalytic application. Int. J. Environ. Anal. Chem. 2022. [Google Scholar] [CrossRef]
- Liang, Q.H.; Shi, Y.; Ma, W.J.; Li, Z.; Yang, X.M. Enhanced photocatalytic activity and structural stability by hybridizing Ag3PO4 nanospheres with graphene oxide sheets. Phys. Chem. Chem. Phys. 2012, 14, 15657–15665. [Google Scholar] [CrossRef]
- Nawaz, M.; Mou, F.; Xu, L.; Guan, J. Effect of solvents and reaction parameters on the morphology of Ta2O5 and photocatalytic activity. J. Mol. Liquids 2018, 269, 211–216. [Google Scholar] [CrossRef]
- Babayevska, N.; Przysiecka, L.; Iatsunskyi, I.; Nowaczyk, G.; Jarek, M.; Janiszewska, E.; Jurga, S. ZnO size and shape effect on antibacterial activity and cytotoxicity profile. Sci. Rep. 2022, 12, 8148. [Google Scholar] [CrossRef]
- Yamamoto, O. Influence of particle size on the antibacterial activity of zinc oxide. Int. J. Inorg. Mater. 2013, 3, 643–646. [Google Scholar] [CrossRef]
- Baig, U.; Gondal, M.A.; Ansari, M.A.; Dastageer, M.A.; Sajid, M.; Falath, W.S. Rapid synthesis and characterization of advanced ceramic-polymeric nanocomposites for efficient photocatalytic decontamination of hazardous organic pollutant under visible light and inhibition of microbial biofilm. Ceram. Int. 2021, 47, 4737–4748. [Google Scholar]
- González, S.C.E.; Bolaina-Lorenzo, E.; Pérez-Trujillo, J.J.; Puente-Urbina, B.A.; Rodríguez-Fernández, O.; Fonseca-García, A.; Betancourt-Galindo, R. Antibacterial and anticancer activity of ZnO with different morphologies: A comparative study. 3 Biotech 2021, 11, 68. [Google Scholar] [CrossRef] [PubMed]
- Song, C.; Labhasetwar, V.; Cui, X.; Underwood, T.; Levy, R.J. Arterial uptake of biodegradable nanoparticles for intravascular local drug delivery: Results with an acute dog model. J. Control. Release 1998, 54, 201–211. [Google Scholar] [CrossRef]
- Barua, S.; Mitragotri, S. Challenges associated with Penetration of Nanoparticles across Cell and Tissue Barriers: A Review of Current Status and Future Prospects. Nano Today 2014, 9, 223–243. [Google Scholar] [CrossRef] [PubMed]
- Contini, C.; Hindley, J.W.; Macdonald, T.J.; Barritt, J.D.; Ces, O.; Quirke, N. Size dependency of gold nanoparticles interacting with model membranes. Commun. Chem. 2020, 3, 130. [Google Scholar] [CrossRef] [PubMed]
- Nawaz, M.; Almofty, S.A.; Qureshi, F. Preparation, formation mechanism, photocatalytic, cytotoxicity and antioxidant activity of sodium niobate nanocubes. PLoS ONE 2018, 13, e0204061. [Google Scholar] [CrossRef] [PubMed]
- El Rayes, S.M.; Aboelmagd, A.; Gomaa, M.S.; Ali, I.A.I.; Fathalla, W.; Pottoo, F.; Khan, F.A. Convenient synthesis and anticancer activity of methyl 2-[3-(3-Phenyl-quinoxalin-2-ylsulfanyl)propanamido]alkanoates and N-Alkyl 3-((3-Phenyl-quinoxalin-2-yl)sulfanyl) propanamides. ACS Omega 2019, 4, 18555–18566. [Google Scholar] [CrossRef] [PubMed]
- Khan, F.A.; Lammari, N.; Muhammad, S.A.S.; Alkhater, K.M.; Asiri, S.; Akhtar, S.; Almansour, I.; Alamoudi, W.; Haroun, W.; Louaer, W.; et al. Quantum dots encapsulated with curcumin inhibit the growth of colon cancer, breast cancer and bacterial cells. Nanomedicine 2020, 15, 969–980. [Google Scholar] [CrossRef]
- Almofty, S.A.; Nawaz, M.; Qureshi, F.; Al-Mutairi, R. Hydrothermal Synthesis of β-Nb2ZnO6 Nanoparticles for Photocatalytic Degradation of Methyl Orange and Cytotoxicity Study. Int. J. Mol. Sci. 2022, 23, 4777. [Google Scholar] [CrossRef]
- Nawaz, M.; Ansari, M.A.; Pérez Paz, A.; Hisaindee, S.; Qureshi, F.; Ul-Hamid, A.; Hakeem, A.; Taha, M. Sonochemical synthesis of ZnCo2O4/Ag3PO4 heterojunction photocatalysts for the degradation of organic pollutants and pathogens: A combined experimental and computational study. New J. Chem. 2022, 46, 14030–14042. [Google Scholar] [CrossRef]
- Ansari, M.A.; Kalam, A.; Al-Sehemi, A.G.; Alomary, M.N.; AlYahya, S.; Aziz, M.K.; Srivastava, S.; Alghamdi, S.; Akhtar, S.; Almalki, H.D.; et al. Counteraction of biofilm formation and antimicrobial potential of Terminalia catappa functionalized silver nanoparticles against Candida albicans and multidrug-resistant gram-negative and gram-positive bacteria. Antibiotics 2021, 10, 725. [Google Scholar] [CrossRef]
- Ansari, M.A.; Akhtar, S.; Rauf, M.A.; Alomary, M.N.; AlYahya, S.; Alghamdi, S.; Almessiere, M.A.; Baykal, A.; Khan, F.; Adil, S.F.; et al. Sol-gel synthesis of dy-substituted Ni0. 4Cu0. 2Zn0. 4 (Fe2-xDyx) O4 nano spinel ferrites and evaluation of their antibacterial, antifungal, antibiofilm and anticancer potentialities for biomedical application. Int. J. Nanomed. 2021, 16, 5633. [Google Scholar]
- Khan, F.A.; Akhtar, S.; Almohazey, D.; Alomari, M.; Almofty, S.A.; Eliassari, A. Fluorescent magnetic submicronic polymer (FMSP) nanoparticles induce cell death in human colorectal carcinoma cells. Artif. Cells Nanomed. Biotechnol. 2018, 46 (Suppl. S3), S247–S253. [Google Scholar] [CrossRef] [PubMed]

| Nanoparticles | Zeta Potential (mV) | Particle Size (nm) | Polydispersity Index (PDI) |
|---|---|---|---|
| Ag3PO4 | −40.1 ± 6.63 | 115 | 0.509 |
| Se-Ag3PO4 | −5.24 ± 10.8 | 458 | 1.00 |
| Ag-Ag3PO4 | −46.6 ± 4.77 | 426 | 0.949 |
| Ta-Ag3PO4 | −79.8 ± 7.96 | 82.78 | 0.594 |
| E. coli | S. aureus | |||
|---|---|---|---|---|
| MIC | MBC | MIC | MBC | |
| Ag3PO4 | 1.0 ± 0.0 | 2 ± 0.0 | 2 ± 0.0 | 4 ± 0.0 |
| Se-Ag3PO4 | 8 ± 0.0 | 16 ± 0.0 | 4 ± 0.0 | 8 ± 0.0 |
| Ag-Ag3PO4 | 0.125 ± 0.0 | 0.5 ± 0.0 | 2 ± 0.0 | 8 ± 0.0 |
| Ta-Ag3PO4 | 0.25 ± 0.0 | 1 ± 0.0 | 4 ± 0.0 | 8 ± 0.0 |
Publisher’s Note: MDPI stays neutral with regard to jurisdictional claims in published maps and institutional affiliations. |
© 2022 by the authors. Licensee MDPI, Basel, Switzerland. This article is an open access article distributed under the terms and conditions of the Creative Commons Attribution (CC BY) license (https://creativecommons.org/licenses/by/4.0/).
Share and Cite
Qureshi, F.; Nawaz, M.; Ansari, M.A.; Khan, F.A.; Berekaa, M.M.; Abubshait, S.A.; Al-Mutairi, R.; Paul, A.K.; Nissapatorn, V.; de Lourdes Pereira, M.; et al. Synthesis of M-Ag3PO4, (M = Se, Ag, Ta) Nanoparticles and Their Antibacterial and Cytotoxicity Study. Int. J. Mol. Sci. 2022, 23, 11403. https://doi.org/10.3390/ijms231911403
Qureshi F, Nawaz M, Ansari MA, Khan FA, Berekaa MM, Abubshait SA, Al-Mutairi R, Paul AK, Nissapatorn V, de Lourdes Pereira M, et al. Synthesis of M-Ag3PO4, (M = Se, Ag, Ta) Nanoparticles and Their Antibacterial and Cytotoxicity Study. International Journal of Molecular Sciences. 2022; 23(19):11403. https://doi.org/10.3390/ijms231911403
Chicago/Turabian StyleQureshi, Faiza, Muhammad Nawaz, Mohammad Azam Ansari, Firdos Alam Khan, Mahmoud M. Berekaa, Samar A. Abubshait, Rayyanah Al-Mutairi, Alok K. Paul, Veeranoot Nissapatorn, Maria de Lourdes Pereira, and et al. 2022. "Synthesis of M-Ag3PO4, (M = Se, Ag, Ta) Nanoparticles and Their Antibacterial and Cytotoxicity Study" International Journal of Molecular Sciences 23, no. 19: 11403. https://doi.org/10.3390/ijms231911403
APA StyleQureshi, F., Nawaz, M., Ansari, M. A., Khan, F. A., Berekaa, M. M., Abubshait, S. A., Al-Mutairi, R., Paul, A. K., Nissapatorn, V., de Lourdes Pereira, M., & Wilairatana, P. (2022). Synthesis of M-Ag3PO4, (M = Se, Ag, Ta) Nanoparticles and Their Antibacterial and Cytotoxicity Study. International Journal of Molecular Sciences, 23(19), 11403. https://doi.org/10.3390/ijms231911403

